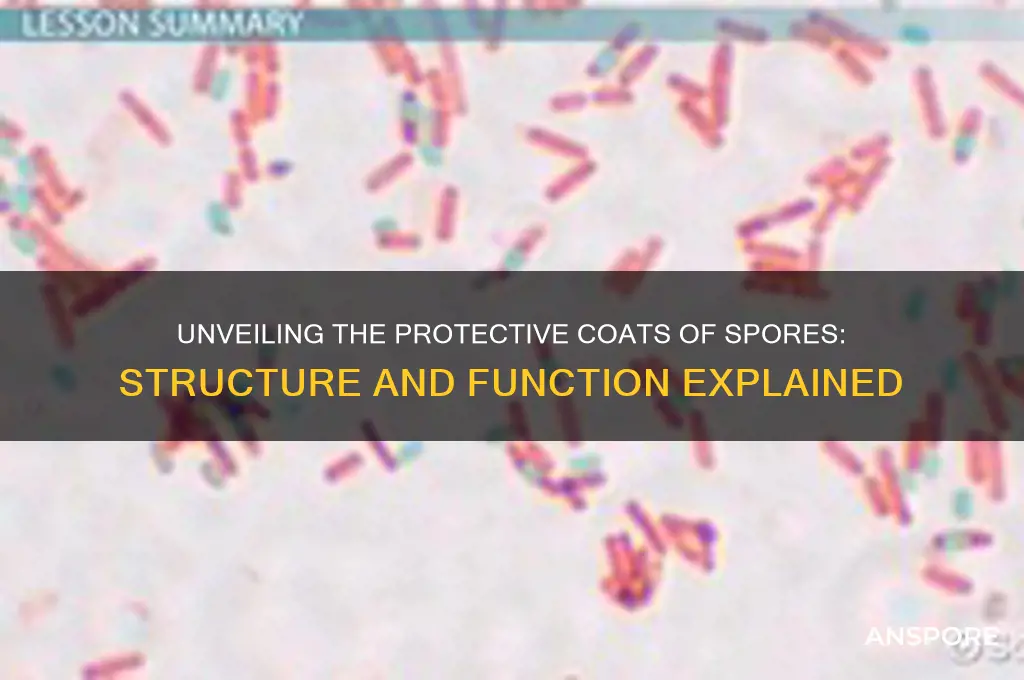
do spores have coats

Spores, the reproductive units of many fungi, plants, and some bacteria, often possess protective outer layers known as coats or walls. These structures serve as a crucial defense mechanism, shielding the spore from harsh environmental conditions such as desiccation, UV radiation, and predation. The composition and thickness of these coats vary widely among species, with some featuring multiple layers or specialized components like pigments and polymers. Understanding the presence and function of spore coats is essential for studying spore survival, dispersal, and their role in ecosystems, as well as for applications in agriculture, medicine, and biotechnology.
Explore related products
What You'll Learn
- Spore Coat Composition: Chemical makeup and layers of spore coats in different organisms
- Protective Functions: How spore coats shield against UV, heat, and desiccation
- Coat Formation Process: Mechanisms and stages of spore coat development
- Species Variations: Differences in spore coats across bacteria, fungi, and plants
- Coat Role in Germination: How spore coats influence dormancy and activation processes

Spore Coat Composition: Chemical makeup and layers of spore coats in different organisms
Spores, the resilient survival structures of various organisms, are often encased in protective coats that shield them from environmental stresses. These coats are not uniform across species; their composition and layering vary significantly, reflecting the unique challenges each organism faces. For instance, bacterial endospores, such as those of *Bacillus subtilis*, possess a multi-layered coat composed primarily of proteins, with over 70 different coat proteins identified. These proteins are organized into an inner and outer layer, each contributing to the spore’s durability against heat, desiccation, and chemicals. In contrast, fungal spores, like those of *Aspergillus*, have coats enriched with melanin, a pigmented polymer that provides UV resistance and structural integrity. This diversity in composition highlights the adaptive evolution of spore coats to ensure survival in specific environments.
To understand the chemical makeup of spore coats, consider the role of lipids and polysaccharides in addition to proteins. In plant spores, such as those of ferns, the coat often contains sporopollenin, a highly resistant biopolymer composed of fatty acids, phenols, and carotenoids. This complex mixture renders the spore impermeable to water and resistant to degradation, ensuring long-term viability. Similarly, algal spores, like those of *Chlamydomonas*, have coats with a high lipid content, which aids in buoyancy and protection against osmotic stress. These chemical components are not randomly distributed but are strategically layered to maximize protection. For example, the outermost layer of a spore coat often contains hydrophobic compounds to repel water, while inner layers may include enzymes or antioxidants to combat oxidative damage.
A comparative analysis of spore coats reveals intriguing adaptations to environmental pressures. Bacterial endospores, with their protein-rich coats, excel in surviving extreme temperatures and radiation, making them a model for studying astrobiology. Fungal spores, on the other hand, leverage melanin’s versatility to withstand UV radiation and predation, a trait particularly useful in surface-dwelling species. Plant spores prioritize mechanical strength and chemical resistance, given their need to travel through air and soil. These differences underscore the principle that spore coat composition is a direct response to the organism’s ecological niche. For researchers, understanding these variations can inform applications in biotechnology, such as developing spore-based delivery systems for vaccines or agricultural treatments.
Practical insights into spore coat composition can guide efforts to manipulate or enhance spore resilience. For instance, in agriculture, coating seeds with sporopollenin-like materials could improve germination rates in harsh conditions. In medicine, engineering bacterial spores with modified coat proteins could create more effective probiotics or drug carriers. However, caution is necessary when altering natural compositions, as changes may inadvertently reduce spore viability or introduce unintended environmental impacts. For hobbyists or students experimenting with spores, observing coat structures under a microscope can provide a tangible appreciation of their complexity. Using stains like Calcofluor White to highlight polysaccharides or Sudan Black for lipids can reveal the layered architecture of these protective barriers.
In conclusion, the chemical makeup and layering of spore coats are as diverse as the organisms that produce them, each tailored to specific survival needs. From protein-rich bacterial endospores to melanin-fortified fungal spores, these structures exemplify nature’s ingenuity in protecting life. By studying their composition, we not only gain insights into evolutionary adaptations but also unlock practical applications across fields. Whether for scientific research or personal exploration, the spore coat remains a fascinating subject that bridges biology, chemistry, and ecology.
Can Grass-Type Pokémon Be Spore'd? Exploring Sleep-Inducing Moves
You may want to see also

Protective Functions: How spore coats shield against UV, heat, and desiccation
Spores, the resilient survival structures of certain bacteria, fungi, and plants, are encased in protective coats that serve as their first line of defense against harsh environmental conditions. These coats are not merely passive barriers but complex, multi-layered structures engineered to withstand specific threats, including ultraviolet (UV) radiation, extreme heat, and desiccation. Each layer of the spore coat is composed of specialized proteins, pigments, and polymers that work in concert to provide tailored protection. For instance, the outer layer often contains UV-absorbing pigments, while the inner layers may include hydrophilic compounds that retain moisture, ensuring the spore’s genetic material remains intact even in arid conditions.
Consider the challenge of UV radiation, which can damage DNA and render spores nonviable. Spore coats contain melanin-like pigments and other UV-absorbing compounds that act as natural sunscreen, filtering out harmful wavelengths. Studies show that spores exposed to UV radiation without these protective coats lose viability within minutes, while coated spores can survive hours or even days under the same conditions. This mechanism is particularly crucial for spores in high-altitude or desert environments, where UV exposure is intense. For practical applications, understanding this protective function can inform strategies for preserving spores in agricultural or industrial settings, such as coating seed banks with UV-protective materials.
Heat resistance is another critical function of spore coats, especially for organisms in fire-prone ecosystems. The coats contain heat-shock proteins and cross-linked polymers that form a rigid, heat-resistant shell. When exposed to temperatures exceeding 100°C, unprotected cells denature rapidly, but spores with intact coats can survive for extended periods. For example, *Bacillus subtilis* spores can endure temperatures up to 120°C for over an hour due to their coat’s insulating properties. This heat resistance is not just a survival mechanism but also a reproductive strategy, as spores can germinate after fires, colonizing nutrient-rich, competition-free environments.
Desiccation, or extreme dryness, poses a unique threat by disrupting cellular structures and metabolic processes. Spore coats combat this through a combination of hydrophobic and hygroscopic layers. The outer hydrophobic layer repels water, preventing rapid moisture loss, while the inner hygroscopic layer retains residual water molecules, maintaining a minimal hydration level essential for survival. Experiments have shown that spores without coats lose viability within days in dry conditions, whereas coated spores can persist for decades or even centuries. This is why ancient spores have been revived from amber and permafrost, showcasing the coat’s unparalleled protective capability.
In practical terms, the protective functions of spore coats offer valuable lessons for biotechnology and conservation. For instance, engineers are developing spore-inspired coatings for electronics and pharmaceuticals to enhance their durability in extreme conditions. Farmers can use spore-based bioinoculants with robust coats to improve crop resilience in arid or UV-intensive regions. By mimicking nature’s design, we can create solutions that are both sustainable and highly effective. The spore coat, a marvel of evolutionary engineering, reminds us that protection often lies in the layers we cannot see.
Best Places to Buy Spores: A Comprehensive Guide for Enthusiasts
You may want to see also

Coat Formation Process: Mechanisms and stages of spore coat development
Spores, the resilient survival structures of various organisms, are not naked entities but are often encased in protective coats. These coats are critical for withstanding harsh environmental conditions, from desiccation to UV radiation. The formation of these coats is a complex, highly regulated process that varies across species, yet shares common mechanistic themes. Understanding this process not only sheds light on spore biology but also has practical implications for fields like agriculture, medicine, and biotechnology.
Mechanisms of Coat Formation: A Layered Approach
Spore coat development begins with the precise deposition of layers, each composed of specific proteins, polysaccharides, and pigments. In *Bacillus subtilis*, for instance, the coat comprises over 70 proteins arranged in an outer, middle, and inner layer. The assembly is orchestrated by molecular chaperones and scaffold proteins that ensure correct folding and localization. For example, the CotE protein acts as a master regulator, triggering the expression of coat proteins in response to environmental cues like nutrient depletion. This layered architecture is not arbitrary; each stratum contributes unique properties, such as hydrophobicity or elasticity, tailored to the spore’s ecological niche.
Stages of Development: From Nucleation to Maturation
Coat formation proceeds in distinct stages, starting with nucleation, where initial proteins bind to the spore’s outer membrane. This is followed by elongation, where layers extend and interlink, forming a cohesive structure. Maturation involves cross-linking and hardening, often mediated by enzymes like transglutaminases, which create covalent bonds between proteins. In fungi, such as *Aspergillus*, melanin is incorporated during this stage, providing UV resistance. Each stage is temporally and spatially controlled, ensuring the coat’s integrity without compromising spore functionality.
Environmental Triggers and Regulatory Networks
Coat development is not an isolated process but is tightly coupled with environmental signals. In *Arabidopsis thaliana*, pollen coat formation is induced by drought stress, with lipid-rich exines providing desiccation tolerance. Similarly, bacterial spores initiate coat synthesis during the transition to stationary phase, a response to nutrient scarcity. Regulatory networks, often involving sigma factors (e.g., σ^K^ in *B. subtilis*), fine-tune gene expression, ensuring resources are allocated efficiently. Disrupting these networks, such as by knocking out key regulators, results in malformed coats and reduced spore viability, underscoring their critical role.
Practical Applications and Engineering Opportunities
Understanding coat formation has practical implications for spore-based technologies. For example, engineering spore coats to encapsulate vaccines or enzymes could enhance stability and delivery. In agriculture, modifying pollen coats to improve drought resistance could boost crop yields. Researchers are exploring synthetic biology approaches, such as expressing heterologous coat proteins or incorporating novel materials like graphene oxide. However, challenges remain, including maintaining spore germination efficiency and avoiding immunogenic responses in biomedical applications.
Comparative Insights: Diversity in Coat Strategies
While the core principles of coat formation are conserved, the specifics vary widely. Bacterial endospores prioritize heat resistance, fungal spores emphasize UV protection, and plant pollen coats focus on adhesion and hydration. These adaptations reflect evolutionary pressures and ecological roles. For instance, the thick, melanized coats of *Cryptococcus neoformans* spores enable survival in mammalian hosts, while the lipid-rich coats of *Pinus* pollen facilitate wind dispersal. Comparative studies highlight the versatility of coat structures and their potential as targets for species-specific interventions.
Exploring Spores: Nature's Ingenious Dispersal Mechanism for Survival and Spread
You may want to see also
Explore related products

Species Variations: Differences in spore coats across bacteria, fungi, and plants
Spore coats are not one-size-fits-all. Across bacteria, fungi, and plants, these protective layers exhibit remarkable diversity in composition, structure, and function, reflecting the unique survival strategies of each group. Bacterial spores, for instance, are encased in a multi-layered coat composed primarily of proteins, which provide resistance to heat, desiccation, and chemicals. In *Bacillus subtilis*, the coat consists of over 70 proteins arranged in an outer, inner, and underlayer, each contributing to spore durability. This complexity ensures bacterial spores can endure extreme conditions, from soil to the human gut.
Fungal spores, in contrast, often feature coats rich in melanin, a pigment that offers protection against UV radiation and predation. For example, the spores of *Aspergillus niger* have a melanized coat that enhances their survival in harsh environments. Additionally, fungal spore coats may contain chitin, a polysaccharide that provides structural integrity. These adaptations allow fungal spores to disperse widely and persist in diverse habitats, from decaying wood to airborne environments.
Plant spores, particularly those of ferns and mosses, have coats optimized for dispersal and germination. The exine and intine layers of pollen grains, for instance, are composed of sporopollenin, a highly resistant biopolymer that protects the genetic material during transport. In mosses, spore coats are often thin but coated with lipids and proteins that facilitate hydration and germination upon landing in suitable substrates. These variations highlight how plant spore coats are tailored to support the life cycle stages of sporophyte and gametophyte alternation.
Understanding these species-specific differences in spore coats has practical applications. For example, in agriculture, knowing the composition of fungal spore coats can inform the development of targeted fungicides. In medicine, bacterial spore coat proteins are being studied for their potential in vaccine design. For hobbyists cultivating plants, recognizing the role of sporopollenin in pollen grains can guide pollination techniques for better seed production. Each coat variation is a testament to the evolutionary ingenuity of spores, ensuring their survival and dispersal across ecosystems.
In summary, the spore coats of bacteria, fungi, and plants are not merely protective barriers but sophisticated structures evolved to meet specific ecological demands. From protein-rich bacterial coats to melanized fungal layers and sporopollenin-based plant coats, these variations underscore the diversity of life’s strategies for persistence and propagation. By studying these differences, we gain insights into both fundamental biology and applied sciences, from biotechnology to conservation.
Can C. Diff Spores Be Inhaled? Understanding Airborne Transmission Risks
You may want to see also

Coat Role in Germination: How spore coats influence dormancy and activation processes
Spore coats are not merely protective shells; they are dynamic structures that play a pivotal role in regulating dormancy and germination. Composed of layers rich in proteins, lipids, and polysaccharides, these coats act as gatekeepers, controlling water uptake, enzyme activity, and environmental signaling. For instance, in *Bacillus subtilis* spores, the coat’s outer crust and inner layers selectively permit or restrict access to nutrients and triggers, ensuring germination occurs only under optimal conditions. This intricate design underscores the coat’s function as both a shield and a regulator, balancing survival with activation.
Consider the germination process as a series of steps, each influenced by the spore coat’s properties. Step one: hydration. The coat’s hydrophobic or hydrophilic nature dictates how water penetrates, a critical factor for activating dormant enzymes. Step two: nutrient sensing. Coats often contain receptors that detect specific molecules, such as L-alanine in bacterial spores, which initiate biochemical pathways leading to germination. Step three: mechanical disruption. In some fungi, coats must be physically weakened by environmental factors like heat or chemicals before germination can proceed. Each step highlights the coat’s role in orchestrating a precise sequence of events.
A comparative analysis reveals how coat composition varies across species, reflecting adaptations to specific environments. For example, plant spores like those of ferns have coats rich in sporopollenin, a durable polymer that resists degradation, ensuring long-term dormancy in harsh conditions. In contrast, fungal spores often have coats with chitin, which provides flexibility for rapid germination when conditions improve. Bacterial spores, such as those of *Clostridium*, have coats with germinant receptors tailored to specific nutrients, ensuring germination only in nutrient-rich environments. These differences illustrate how coat composition is finely tuned to species-specific survival strategies.
Practical applications of understanding spore coats extend to fields like agriculture, medicine, and food safety. For instance, controlling germination in plant spores can enhance seed longevity and viability, benefiting crop storage and distribution. In medicine, disrupting bacterial spore coats could lead to novel antimicrobial strategies, particularly against pathogens like *Clostridioides difficile*. In food safety, inhibiting germination of spoilage spores in canned goods could extend shelf life. To apply this knowledge, researchers can experiment with coat-targeting compounds, such as chitinases for fungal spores or germinant antagonists for bacterial spores, at concentrations as low as 1–10 μM, depending on the species and desired effect.
In conclusion, the spore coat is not a passive barrier but an active participant in the dormancy and germination processes. Its structure and composition dictate how and when a spore awakens, ensuring survival in diverse environments. By studying these mechanisms, scientists can unlock new ways to manipulate spore behavior, with implications ranging from improved crop yields to advanced antimicrobial therapies. Understanding the coat’s role is thus essential for harnessing the potential of spores across multiple disciplines.
Can Mold Spores Get on Your Hands? Understanding Risks and Prevention
You may want to see also
Frequently asked questions
No, not all spores have coats. While many spores, such as those of fungi and some bacteria, possess protective coats, others like certain plant spores may lack them.
A spore coat serves as a protective barrier, shielding the spore from environmental stresses such as desiccation, UV radiation, and predators, ensuring its survival until favorable conditions for germination arise.
No, spore coats vary in composition depending on the organism. For example, fungal spore coats often contain chitin, while bacterial endospores have coats made of proteins and peptidoglycan.
Yes, spore coats can be penetrated or removed under specific conditions, such as through mechanical, chemical, or enzymatic treatments, which is often necessary for spore germination or laboratory analysis.
Yes, spore coats play a crucial role in germination by regulating the entry of water and nutrients. In some cases, the coat must be weakened or removed for germination to occur.

























